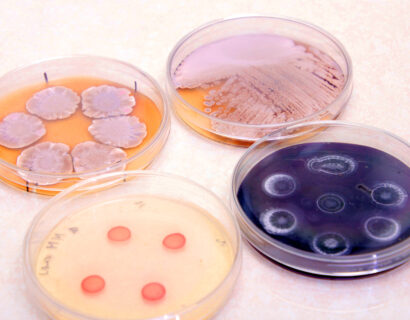
Laboratorium Biotechnologii

Secretary
MSc Anna Wysocka
telephones: direct 071 370 99 48; 071 337 11 72 wew. 175
room: 263
email: anna.wysocka@hirszfeld.pl
Laboratories
Biotechnology Laboratory
In the Biotechnology Laboratory, we deal with the Streptomyces - an interesting group of bacteria with a complex life cycle, ...

Laboratory of Microbiome Immunobiology
The leading topic of the Laboratory is to determine the mechanisms of the interaction of microorganisms that create the microflora ...

Laboratory of Molecular Biology of Microorganisms
We study fundamental cellular processes and mechanisms that enable bacteria to adapt to their environments, such as chromosome replication, the ...
